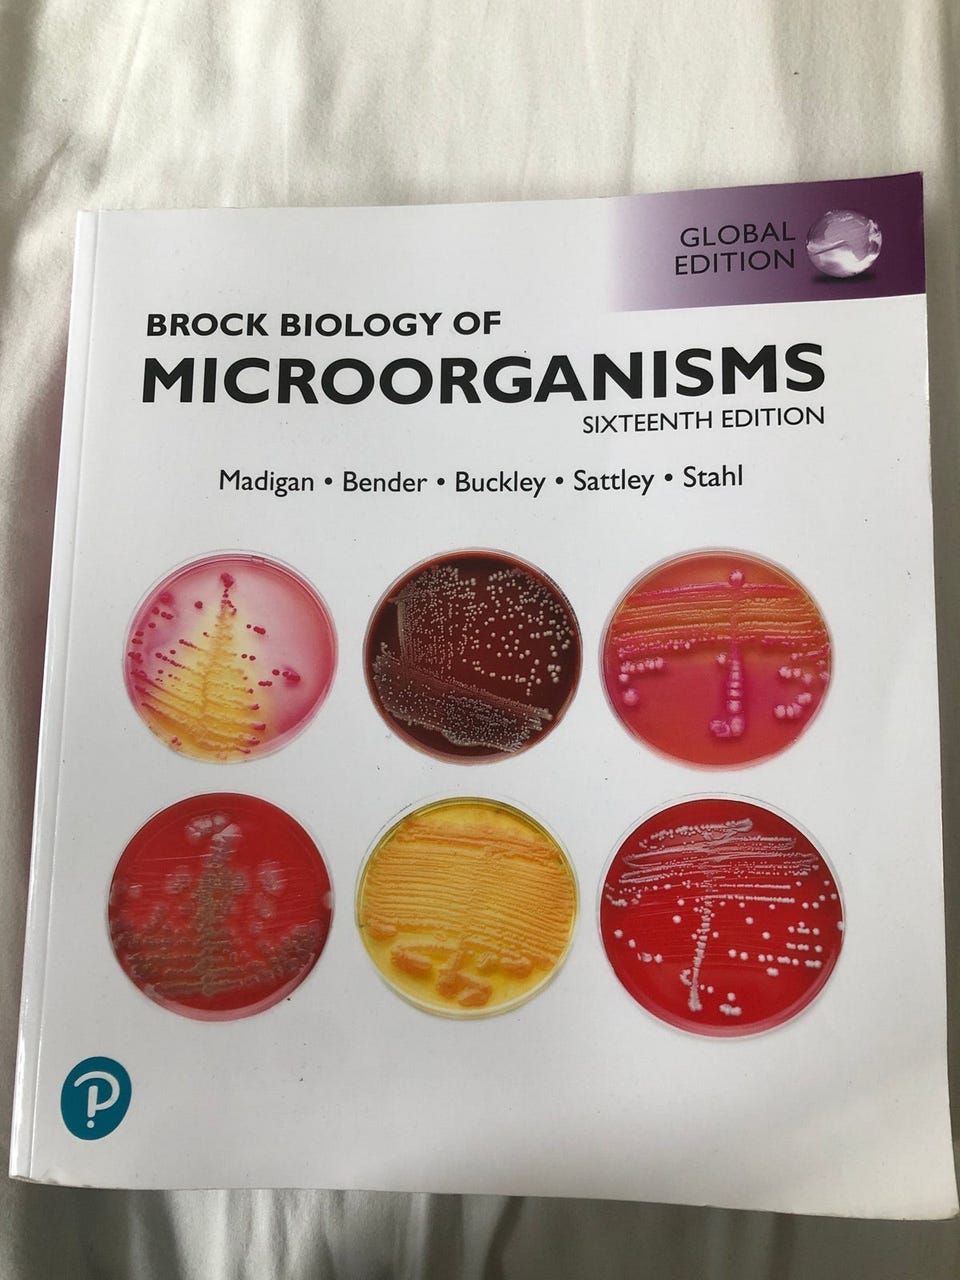
Galleribillede

Fiks færdig
Billedgalleri
(1/1)
Brock biology of microorganisms, emne: biologi og botanik
Til salg
250 kr.
Bed sælgeren om at sende med Fiks færdig! Det er trygt, hurtigt, og varen vil blive sendt til dig. Læs mere
Varebeskrivelse
Emne: Biologi
Brock biology of microorganisms, emne: biologi og botanik, 16. Udgave i god stand
Bemærk: Knappen til at vise den fulde beskrivelse har kun en visuel effekt.
Brugerprofil
Du skal være logget ind for at se brugerprofiler og sende beskeder.
Log indAnnoncens metadata
Sidst redigeret: 22.12.2024 kl. 10:46 ・ Annonce-ID: 5142228